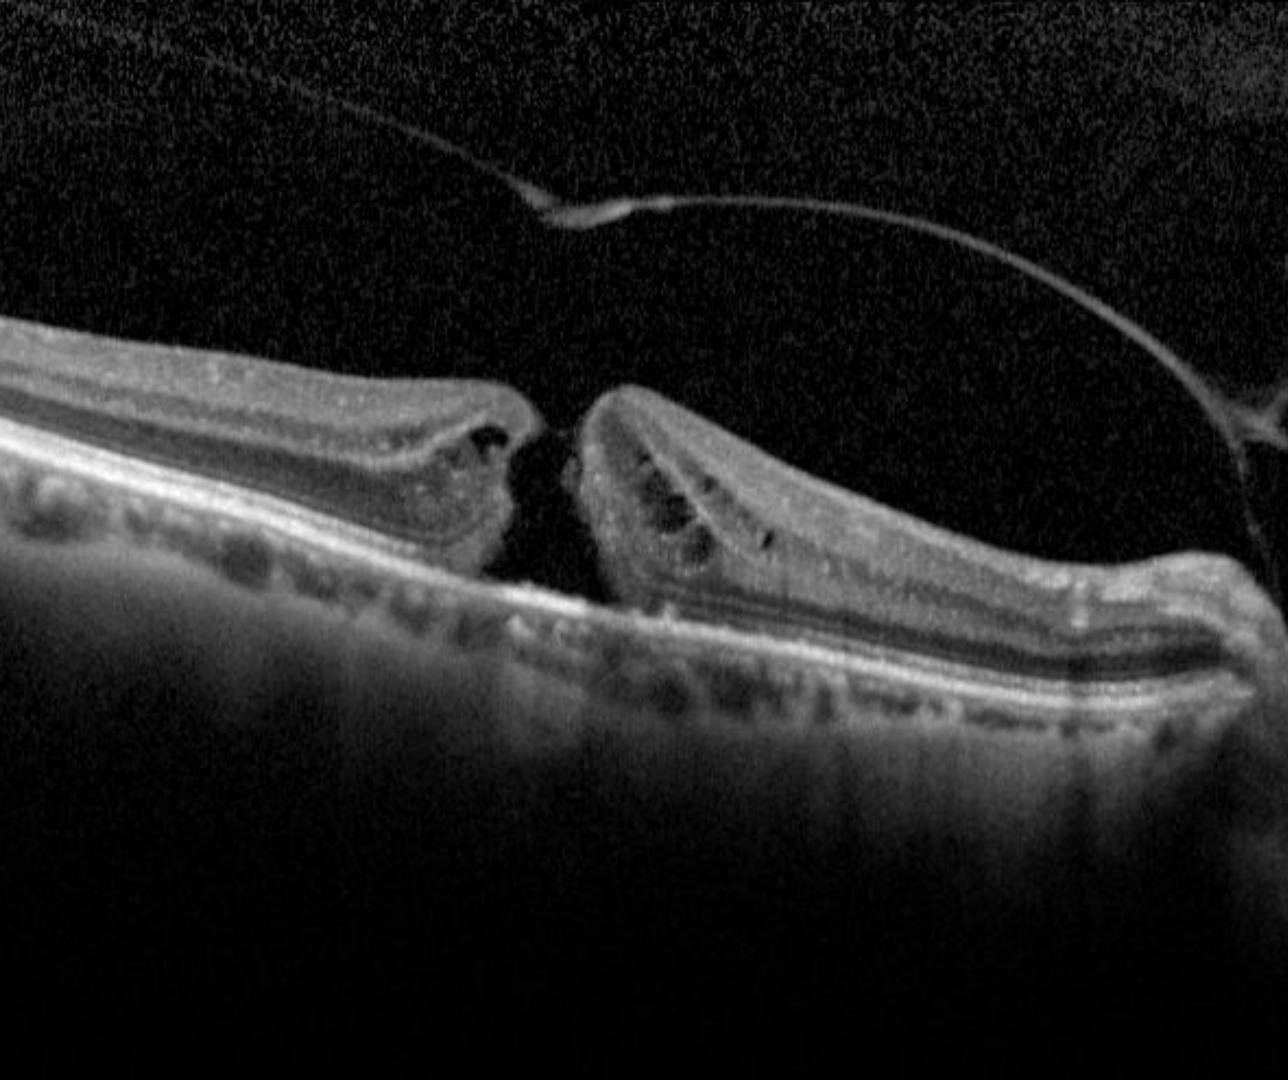

Overview
Full thickness macular hole (FTMH) is a full thickness break at the fovea and can be caused by tractional forces from the vitreous, ERM or trauma.
OCT shows loss of all the foveal layers from the internal limiting membrane up to (but not including) the RPE. The edge of the hole is rounded and may contain pseudocysts. The International Vitreomacular Traction Study Classification System for Mitreomacular Adhesion, Traction and Macular Hole developed a classification system for classifying a hole size by OCT measurement of its narrowest aperture.
Small: ≤250µm
Medium: >250µm- ≤400µm
Large>400µm
Clinically, it will appear as a round red lesion at the central macula.
Idiopathic macular hole caused by vitreous traction at the fovea is the most common type of macular hole and typically found in older populations.
Traumatic macular hole is the second most common type of macular hole and most common in younger populations. In some cases, a traumatic macular hole may spontaneously resolve.
Case Examples
-
Case 1: Large FTMH
A 70 year old Asian female with best corrected visual acuity of 6/60 (20/200) - pinhole yielded no improvement.
-
Case 2: Small FTMH
A 67 year old Caucasian female with best corrected visual acuity of 6/15- (20/50-) in the right eye.
-
Case 3: Small FTMH
An 81 year old Caucasian female with best corrected visual acuity of 6/15- (20/50-) in the left eye (pinhole no improvement).
-
Case 5: Small FTMH
A 59 year old Asian female with best corrected visual acuity of 6/12 (20/40) in the left eye.
-
Case 5: Progression to FTMH
A 58 year old Asian female with high myopia initially presented with best corrected visual acuity of 6/12 (20/40).
Differential Diagnosis
References
Stalmans, P. Duker, J. Kaiser, PK. Heier, JS. Dugel, P et al. (2013) OCT-Based interpretation of the vitreomacular interface and indications for pharmacologic vitreolysis. Retina Volume 33 - Issue 10


